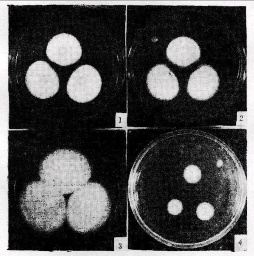
JWXT1995020090001_s

【作者】徐家立;张军;齐祖同;
【机构】中国科学院微生物研究所;中国科学院微生物研究所 北京 100080;
【摘要】从242株青霉属菌株中筛选出脂肪酶产生菌青霉-PG3。经鉴定,定名为卡门柏青霉(Penicillium camembertii Thom)。卡门柏青霉-PG3在由4%豆饼粉,0.5%糊精,0.75%橄榄油,0.5%K2HPO4,0.1%(NH4)2SO4组成的液体培养基中,28℃,振荡培养96小时,发酵液脂肪酶活力(39℃,pH7.0)达60U/ml。PG3脂肪酶以橄榄油为底物,水解反应最适温度为48℃,最适pH为8.0。pH稳定范围6.0—11.0。Cu2+,Ca2+,Fe2+,Pb2+等金属离子对酶活力有抑制作用。PG3脂肪酶对椰子油、菜籽油、亚麻油等油脂的水解率分别达到96%,94%和90%。
Manbetx体育手机版V17版本发布.官网安卓网.香港卡门柏青霉;脂肪酶;
【分类号】Q946;
【文内图片】